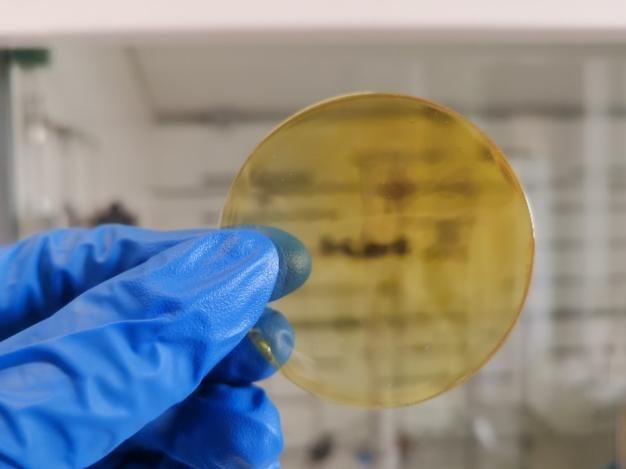

【团队简介】
团队风采:

导师介绍:

马沧海教授:
马沧海,教授,博士生导师,现任大连理工大学化工学院化学工程系副系主任。入选国家级青年人才、辽宁省“兴辽计划”青年拔尖人才、“兴辽英才”博士后储备项目。2006、2008年先后获华中科技大学本科、硕士学位,2012年获美国佐治亚理工学院(Georgia Institute of Technology)化学工程博士学位。博士师从世界著名膜科学家、美国工程院院士William Koros教授,致力于先进膜材料、膜分离技术及其工业应用研究。主要工作以第一或通讯作者发表在Nat. Commun. (2篇)、Adv. Funct. Mater.、AIChE J./Chem. Eng. Sci./Ind. Eng. Chem. Res. (化工三大TOP刊5篇)、Small (2篇)、ACS Appl. Mater. Interfaces、ChemSusChem、J. Membr. Sci. (12篇)等期刊,申请34余项专利,授权10项中国专利、5项美国专利。长期担任Nat. Sustain.、Nat. Commun.、Adv. Mater.、Adv. Funct. Mater.、J. Membr. Sci.、Sep. Purif. Technol.等国际学术期刊审稿人,现任《Green Energy & Environment》、《Advanced Membrane》期刊青年编委。
人才项目:
主要奖励:
IChemE & CCST杰出青年科学家奖(2023)
Results in Engineering工程前沿杰出青年科学家奖(2023)
国际分离纯化技术大会青年膜科学家奖(2022 ,仅6人)
第一届中国科技青年论坛三等奖(2022,大工仅2人)
大连理工大学学术成果奖励(科技)二等奖(2022,排名第1)
大连理工大学化工学院青年教师讲课竞赛一等奖(2022)
项目及学术兼职:
主持国家级青年人才、国家自然科学基金、辽宁省青年拔尖人才、辽宁省联合基金、中央高校基本科研业务费、中核集团等项目
担任Green Energy & Environment、Advanced Membranes等期刊青年编委、Carbon Capture Science & Technology客座编辑
担任国家自然科学基金、教育部人才计划评审专家、中国博士后基金评审专家
长期担任Nat. Sustain.、Nat. Commun.、Adv. Mater.、Adv. Funct. Mater.、J. Membr. Sci.、Sep. Purif. Technol.等国际学术期刊审稿人
研究方向:先进气体分离膜材料、膜分离技术及其工业应用研究
职称:教授,博士生导师
联系方式:13079853592(同微信)
电子邮箱:cma@dlut.edu.cn
团队成员:

李天佑 白露 高泽远 范方旭 王宇傲
博士 博士 博士 博士 博士

王鹏 公静玲 张博文 牛佩瑶 王思尧
博士 博士 博士 研三 研三

张爽 李津宇 魏霖璇 槐子宇 李泽华
研三 研三 研三 研二 研二

卢容钰 吴星悦 苏煜峰 张怡 崔康宁
研二 研二 研一 研一 研一


余满铭 李文飞
研一 研一
课题组目前拥有在读博士9名,在读硕士15名,国际留学生2名。保研学生5名,“拔尖计划”入选学生3名。研究生国家奖学金获得者4人、博士生卓越奖学金获得者1人,硕士生省级优秀毕业生1人,优秀研究生4人,优秀本科生基金1人。
主要研究方向:
膜材料功能化设计与合成:聚酰亚胺,有机微孔聚合物(自具微孔聚合物、热重排聚合物等),炭分子筛,金属有机骨架材料(MOFs)等;
膜设计与制备:混合基质膜,中空纤维膜制备及形成机制,复合中空纤维膜等;
中空纤维膜组件设计与组装:中空纤维膜纺丝技术,膜组件设计、组装与测试;
气体膜分离技术及应用:CO2捕获,天然气浓缩,空气分离,氢气提纯,烯烃/烷烃分离等。
重要成果:
Nature Communications (材料国际著名Nature子刊,IF=16.6)(2篇)
Advanced Functional Materials(材料国际著名期刊,IF=18.5)(1篇)
AIChE J./Chem. Eng. Sci./Ind. Eng. Chem. Res. (化工三大TOP刊,5篇)
Small(国际纳米材料领域顶级期刊,IF=13.0 ) (2篇)
Journal of Membrane Science(膜领域权威期刊, IF=8.4)(12篇)
Separation and Purification Technology(分离领域权威期刊, IF=8.1)(5篇)
申请专利34余项,授权专利15项(5项美国专利和,10项中国发明专利)
【科研展示】
研究方向一:膜材料分子设计及合成
代表论文:Nat. Commun. 2025, 16,133; Nat. Commun. 2021, 12, 6140; AIChE Journal, 2025, e70126; AIChE Journal, 2024, e18471; J. Membr. Sci. 2023, 122115 ; J. Membr. Sci. 2025, 123843

以热能为驱动力的传统工业分离过程(如蒸馏)成本贵、能耗高、体积大,膜分离是一种新型高效分离技术,可有效克服传统分离技术的挑战,缓解全球日益紧张的能源危机,有助于我国实现“碳达峰、碳中和”目标。传统聚合物膜材料存在渗透性-选择性之间此消彼长的tradeoff关系(即Robeson上限),严重制约了膜技术的发展与应用。课题组提出了通过聚合物共聚多重共价交联机制调控膜孔径的策略,制备了孔径在3.5-4 Å间的微孔聚合物,实现了对多种气体的精确、高效筛分,突破2019年气体分离上限(Nat. Commun. 2021, 12, 6140)。
研究方向二:膜材料改性及膜结构设计
代表论文:Adv. Funct. Mater.,2019, 29, 1903243; Small 2025,2411664; Small 2025, 2412158; Chem. Eng. Sci., 306 (2025) 121230; J. Membr. Sci.,722 (2025) 123907

基于无机纳米填料与聚合物制备的有机-无机混合基质膜(Mixed Matrix Membrane),具备超高渗透性和选择性,超越了传统膜材料的渗透性-选择性分离Robeson上限,但存在界面兼容等关键问题。课题组设计了一种超渗透聚酰亚胺/金属有机框架(MOF)混合膜,可实现多种应用(例如二氧化碳捕获和氢气再生)的超快速气体分离,同时提供与当前膜制造工艺的合成增强兼容性。该膜的 CO2 和 H2 渗透性分别为 2494 Barrers 和 2932 Barrers,CO2/CH4、H2/CH4 和 H2/N2 选择性分别为 29.3、34.4 和 23.8,大大超过了目前的 Robeson 渗透性-选择性上限界限。 MOF 负载量为 55 wt% 时,与纯聚合物相比,该膜的 H2 渗透性提高了 16 倍,创历史新高。(Adv. Funct. Mater.,2019, 29, 1903243)
研究方向三:中空纤维膜技术及其工业应用
代表论文:J. Membr. Sci., 551 (2018) 214-221; J. Membr. Sci., 493 (2015) 252-262; Ind. Eng. Chem. Res., 2013, 52 (31) 10495–10505; US9718031 B2(美国授权专利)

聚合物中空纤维膜具有极大的表面积-体积比和较高的渗透性,是当前国际最先进的气体膜分离技术,但在高CO2 浓度下易“溶胀”并塑化而导致性能下降。课题组长期从事先进中空纤维膜技术的研究,通过同时优化纺丝溶液和干喷/湿骤冷纺丝工艺变量,开发了显著改进的无缺陷酯交联中空纤维膜,在恶劣的进料条件下表现出极高的分离效率和抗 CO2 增塑性的功效。CO2 渗透性从 50 GPU 提高到 117 GPU,CO2/CH4 选择性为 37,综合性能超越大多数文献。在高达 800 psi 的进料压力下保持高 CO2 渗透性,克服了 CO2 塑化现象(J. Membr. Sci., 551 (2018) 214-221)。
实验室和科研工作图片:
课题组学习室:
课题组秉承既有科研又有生活的原则,为本科生、研究生提供舒适的工位条件,并配备空调、打印机、微波炉等基本生活设施,同时,课题组气氛融洽、友好,工作环境安静,可以在舒适的环境中进行学习和工作。




课题组实验室:
实验室拥有丰富的实验仪器、测试设备,具有国内外领先的膜表征、测试技术,配备大型设备数十台,可满足多项实验要求。实验室条件干净整洁,无化学异味,科研环境舒适;课题组经费充足,支持学生试验自己的科研想法。

【培养特色】
课题组科研待遇:
课题组在学校基础补助、学院“拔尖计划”等补助的基础上,根据参与课题组工作表现给予奖励,例如协助管理实验室、申请基金项目、发表学术论文专利等根据工作量给予奖励。
学生在课题组内学到的不仅仅是科研知识,从课题组毕业所带走的不仅是一篇、两篇的科研论文成果,更重要是学会独立解决科学问题的能力、在焦头烂额时合理安排时间做到井井有条的能力、在遇到挫折学会勇敢面对攻克艰难的能力、和同门以及导师交流沟通为人处世的能力,将这些都转化为自己的核心素质,将来无论是工作、深造、出国,在各种场合做到游刃有余。
课题组寄语:
在我们课题组,科研是一种全面的学习和成长的体验。不仅能够扩展自己的知识面,还能够锻炼和提高自己的科研能力。我们不只是做实验和写论文,还要学会用正确的角度和逻辑去思考问题。导师,不仅是学识的传授者,更是成长的引路人。他们用宽厚的胸怀,包容我们的稚嫩,用温暖的目光,鼓励我们的成长。同窗,不仅是路上的伙伴,更是精神的共鸣者。我们互相扶持,共同进步。在科研的道路上,我们欣赏科学之美,感悟人生之意。让我们感受到课题组就是一个温馨快乐的大家庭!欢迎你加入我们!
科研工作图片或团队活动图片:


老师带学生做实验、导师与学生打篮球


干净整洁实验条件、庆祝学生生日


先进测试设备、参加国内外学术会议
【育人成果】
课题组主要从事聚合物膜材料和炭分子筛功能膜分离材料研究,就业方向较为广泛,可从事膜领域、高分子聚合物、设计院、分离净化、半导体、传统化工等多个领域,覆盖高科技企业、设计院、科研院校等著名单位。本科生被浙江大学等著名高校录取,研究生毕业签约天津工业大学、万华化学、长江存储、中铝国际沈阳铝镁设计研究院(研究院)等单位。
部分就业学生展示:

孙永超 王笑宇 赵启正
2021-2025年博士研究生 2020-2023年硕士研究生 2021-2024年硕士研究生
去向:天津工业大学教师 去向:沈阳铝镁研究院 去向:烟台万华

张敬发 李泓锦 关荐予
2021-2024年硕士研究生 2022-2025年硕士研究生 2022-2025年硕士研究生
去向:烟台万华 去向:浙江恒逸研究院 去向:浙大读博

孙发珂 刘一钧
2022-2025年硕士研究生 2022-2025年硕士研究生
去向:武汉长江存储 去向:武汉长江存储
【招生事项】
招生类型
硕士推免生(学术学位/专业学位)/硕士统考生(学术学位/专业学位)/直博生(学术学位/专业学位)/硕博连读(学术学位/专业学位)/申请考核制博士生(学术学位/专业学位)
招生导师
硕士生导师:马沧海 教授
博士生导师:马沧海 教授
招生科研方向:智能膜材料与膜过程工程、化工分离工程、
膜科学及过程
招生专业:硕士生:化学工程
博士生:化学工程与技术
联系方式:13079853592(同微信)
电子邮箱:cma@dlut.edu.cn